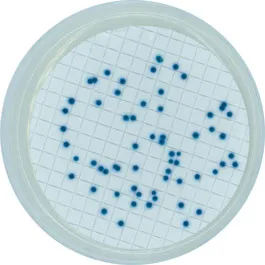

Coliform Agar Base (ISO) Chromogenic Microinstant®
01-797
EN / ISO
Selective and differential medium for the detection and enumeration of coliforms and E. coli in water samples by MF technique according to ISO 9308-1.
Synonyms: CCA, ACC
EN / ISO
Selective and differential medium for the detection and enumeration of coliforms and E. coli in water samples by MF technique according to ISO 9308-1.
Synonyms: CCA, ACC

01-797
EN / ISO
Selective and differential medium for the detection and enumeration of coliforms and E. coli in water samples by MF technique according to ISO 9308-1.
Synonyms: CCA, ACC

Rest of the World
Rest of the World





